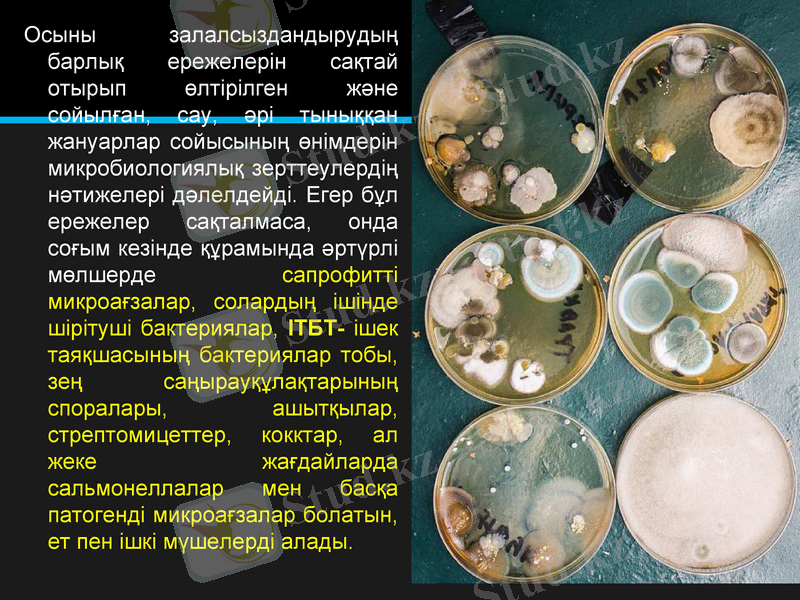
Slide 4

Ет пен жұмыртқаның микробиологиясы: тұқымдану, бұзылу және өнім қауіпсіздігінің көрсеткіштері



Ет және жұмыртқа микрофлорасы
С. Сейфуллин атындағы Қазақ агротехникалық университеті
Биология ғылымдарының кафедрасы
АСТАНА-2018
Орындаған: 203 топ студенті Мылтықбаева Г. А.
Тексерген: Техника ғылымдарының магистрі,
«Микробиология және биотехнология»
кафедрасы ассистенті Қожахметова Д. Д.

Жоспар

Әдетте микроағзалар, жануарлардың қанында, бұлшық еттері мен ішкі мүшелерінің құрамында болмайды.
Еттің микроағзалармен тұқымдануының жолдары мен көздері.
Осыны залалсыздандырудың барлық ережелерін сақтай отырып өлтірілген және сойылған, сау, әрі тыныққан жануарлар сойысының өнімдерін микробиологиялық зерттеулердің нәтижелері дәлелдейді. Егер бұл ережелер сақталмаса, онда соғым кезінде құрамында әртүрлі мөлшерде сапрофитті микроағзалар, солардың ішінде шірітуші бактериялар, ІТБТ- ішек таяқшасының бактериялар тобы, зең саңырауқұлақтарының споралары, ашытқылар, стрептомицеттер, кокктар, ал жеке жағдайларда сальмонеллалар мен басқа патогенді микроағзалар болатын, ет пен ішкі мүшелерді алады.

Еттің микроағзалармен тұқымдануының жолдары мен көздері.

Микроағзалармен эндогенді тұқымдану
Микроағзалармен эндогенді тұқымдану жануардың тірі көзінде де, соғымнан кейін де жүзеге аса алады. Жануарлардың тірі көзінде тұқымдануы инефекциялық аурулармен сырқат жануарларда өтеді, олардың мүшелері мен ұлпаларында аурудың қоздырғышы болады. Қоздырғыштың мүшелер мен ұлпаларға таралуы, инфекцияның түріне, оның ағымы мен сырқат жануар ағзасының жағдайына тәуелді болады.
.

Микроағзалармен экзогенді тұқымдану
Экзогенді тұқымдану, жануарларды сою кезінде және әрі қарай мал етін мүшелеу операцияларын іске асырған кезде орындалады. Экзогенді тұқымданудың көздері

Ет өндірісінің санитарлы-гигиеналық ережелерін сақтаған кезде, жаңа сойылған еттің беткі ауданының 1 см2-на бактериалды жасушалардың бірнеше мыңнан немесе бірнеше он мыңнан артық емес саны есептеледі. Санитарлы жағдайдың төмен көрсеткіштерінде мал сою мен тұтас етті мүшелеу цехтарында, еттің аудандық бетінің 1 см2-на микроағзалардың саны жүз мыңға дейін, тіпті миллионға дейін жетуі әбден мүмкін.

Жаңа ет микрофлорасының сапалық құрамы
Бұл микрофлораның негізгі массасын асқазан-ішек жүйесінде тіршілік ететін микроағзалар құрайды. Ең жиі түрде стафилококктар мен микрококктарды, әртүрлі шірітуші аэробты бациллаларды, анаэробты клостридиялер мен спорасыз бактерияларды, ашытқыларды, сүтқышқылды таяқшаларды, стрептомицеттер мен зең саңырауқұлақтарының спораларын анықтайды. Кейде сальмонеллаларды, сирек жағдайда - басқа патогенді микроағзаларды анықтайды.

Актиномицет споралары
Клостридиялар
Стафилококтар
Микрококтар

Соғым кезінде еттің өңделуі қаншалықты мұқият жүргізілсе де, тұтас еттің бетінде бәрі-бір микроағзалар қалады. Олардың арасында Escherichia coli, Proteus vulgaris, споратүзуші аммонификаторлар Bacillus subtilis, Bacillus mesentericus, Clostridium sporogenes, Clostridium putrificum және басқалары анықталады; жиі жағдайда еттің бетіне саңырауқұлақтардың споралары түседі. Ұлпалардың түбіне микробтар сүйектердің, қан тасымалдаушы түйіршіктердің бойымен өтеді.
Escherichia coli
Clostridium sporogenes

Микроағзалардың белсенді түрде көбейген жағдайында, олардың тіршілігінің нәтижесінде стационарлық фазаның аяғында салқындатылған еттің бұзылуы орын алуы мүмкін. Ет бұзылуларының келесі түрлері анықталады: шырыштануы, шіруі, қышқылдық (қышқыл) ашуы, пигменттену, зеңденуі мен жалтырауы.
Ет бұзылуларының түрлері:

БҰЗЫЛУ ТҮРІ
ШЫРЫШТА-НУ
ШІРУ
ҚЫШҚЫЛДЫ АШУЫ
ТҮСІНІҢ ӨЗГЕРУҢ
ЗЕҢДЕНУ
ЖАЛТЫРАУЫ
Микроорганизмдер
Pseudomonas,
Achromobacter
Lactobacterium
Mycobacterium
Aeromonas
B. рrodigiosum,
Pr. vulgaris,
Ps. fluorescens,
Ps. рyocyanea
Bac. subtilis,
Bac. meseutericus Bac. megatherium
Bac. mycoides
Cl. sporogenes,
Cl. putrificus,
Cl. perfringens
Lactobacterium, Mycobacterium ж/е зең саңырауқұлартары
Ps. fluorescens
Ps. pyocyaneae
Ps. syncyanea,
Bact. prodigiosum сарциналар,
Rhodotorula.
Зең саңырауқұлақтары
Pseudomonas туыстас бактериялар
ЕТТІҢ БҰЗЫЛУЫНА ӘСЕРІН ТИГІЗЕТІН МИКРООРГАНИЗМДЕР

Ет арқылы берілетін азық-түліктік токсикоинфекциялар мен токсикоздар.
Токсикоинфекцияларды сальмонелла тобының бактериялары: Salmonella dublin, Salmonella. typhimurium, Salmonella choleraesuis; шартты-патогенді микрофлоры тобының бактериялары: Е. coli, Proteus vulgaris, кокктар мен басқа микроағзалар тудырады. Токсикоздар тек токсиндердің әсерімен туындайды. Токсикоинфекциялар, токсикоинфекциялардың қоздырғыштарымен инфекцияланған етті тағамға шала піскен күйде тұтынған кезде пайда болады. Еттің сальмонеллалармен инфекциялануы малдың тірі кезінде орын алуы мүмкін, себебі олар жануарлардағы сальмонеллездардың қоздырғыштары болып табылады. Токсикоинфекцияның қоздырғыштары етке санитарлық ережелерді бұзған жағдайда судан, қондырғылардан, құралдардан түсуі мүмкін. Сальмонеллалармен инфекцияланған ет, сырттай ешбір өзгерістерге ие болмайды және өзінің жарамсыздығы бойынша күмән тудырмайды.

Ауру салдың еті инфекцияның, мысалы қарасанның көзі болуы мүмкін, сондықтан сырқаттанған жануардың денесі мен терісін утилизациялайды немесе өртейді. Туляремия сияқты мұндай ауру, жануарлармен байланысқанда да, етін тұтынғанда да беріледі. Ауру мал немесе туляремиямен сырқат деп күдікті болатын жануарлар соғымға жіберілмейді. Адам үшін дәл осындай қауіптілікті үш сүзегімен, лептоспирозбен, саппен, туберкулезбен және т. б. ауыратын малдың еті тудырады. Бруцеллезді малдың соғымын санитарлы қасапханаларда жүргізеді. Жеке профилактика ережелерін сақтамаған жағдайда, ет арқылы союмен айналысатын жұмысшыларда ауру жұқтыруы мүмкін. Адам үшін қой мен ешкілердің бруцеллезі ерекше қауіптілік төндіреді.

Түрлері
КМАФАнМ, КОЕ/г,
Рұқсат етілмейтін өнім массасы. г
БГКП (коли-формалар)
Патогенді микроағзалар
Балғын ет (барлық соғымдық еттер)
10
1, 0
25
Салқындатылған ет
1×103
0, 1
25
Мұздатылған ет
1×104
0. 01
25
Бөлшектелген еттер
5×105
0, 001
25
Сүйегімен қоса өлшегендегі массасы
5×106
0, 0001
25
Ірі қара мен ошқа еті (бөлшектенген)
5×105
0, 001
25
Ет өнімінің қауіпсіздігінің көрсеткіштері

Жұмыртқа микробиологиясы. Жұмыртқа бөлімдері микробтарға әртүрлі төзімділік көрсетеді. Бүлінуге және жұқтырылуға лизоцим атты ферменті бар ақуыз төзімдірек келеді. Аталмыш ферменттің ең көп мөлшері тауықтың ақуызында болады (5, 7 мг/мл), ал үйрек пен қазда бұл көрсеткіш сәйкесінше 3 және 15 есе аз болады.

Сау құстың жұмыртқасында микробтар болмағандықтан, олар ұзақ мерзім бойы стерильді күйін сақтай алады. Жұмыртқаларға микробтар эндогенді және экзогенді жолдармен енеді. Туберкулез, сальмонеллез және басқа инфекцияларға шалдыққан мекиендердің жұмыртқалары эндогенді жолмен жұқтырылады. Өнімнің экзогенді ластануы деп микробтардың қоршаған ортадан жұмыртқа қабығының саңлаулары арқылы ішке енуін айтады. Микробтардың жұмыртқаға ену жылдамдығына температура, ауа ылғалдығы, өнімнің сақталу мерзімі, лизоцимнің белсенділігі, микробтардың жылжу қабілеттілігі және т. б. факторлар әсер етеді. Айталық, 20°С температурада және 80-85% ылғалдылықта Pseudomonos, Proteus 2-5, Salmonella typhimurium 8-11, E. coli 13-15, ал Aspergillus 5-9 тәулік аралығында қабықтың бетінен жұмыртқа ішіне ене алады екен. 15°С температурада және 60-65% ылғалдық жағдайында мезофильді бактериялар жұмыртқаға 11 тәуліктен соң ғана ене алады, ал 10°С толық дерлік тоқтайды. Pseudomonas тобының психрофильді микробтары және зең саңырауқұлақтары нөл градуста да қабық саңылаулары арқылы өтіп кетеді. Әуелі олар қабық астында, сонан соң ақуызда колонияларды түзеді.

Ақуыздың микроб ферменттерінің әсерінен ыдырауы жұмыртқаның шіруіне әкеледі. Бұл процестің келесі түрлері белгілі.
Жасыл шірік жұмыртқаға Pseudomonas туысына жататын микробтардың (Pseudomonas fluorescens және т. б. ) енуінен пайда болады. Олар түзетін пигмент жұмыртқаны жасыл түске бояйды.
Қызыл немесе қызғылт шірікті тек Pseudomonas тұқымының өкілдері ғана емес, сонымен қатар Micrococcus roseus, Serratia marcescens және тағы басқа микроорганизмдер тудырады. Олар бөліп шығаратын пигменттің түсіне сәйкес жұмыртқа қызыл немесе қызғылт түске боялады.
Қара шірікті Proteus vulgaris және Pseudomonas туысының кейбір өкілдері қалыптастырады. Жұмыртқаның ақ уызы мен сары уызы сұйылып, қоңыр немесе қара реңкке ие болады. Пайда болған газдар жұмыртқа қабығын жарып та жібереді.
Аралас шіріктің негізгі себебі - Е. coli, Staphylococcus aureus және басқа микробтар. Жұмыртқаның консистенциясы ғана емес, сонымен қатар түсі де өзгеріске ұшырайды. Әдетте ол сұрғылт тартып, шіріген затқа тән иіс иіс шығарады.

Тауық жұмыртқасының құрылысы: 1 - қабықүсті пленка; 2 - қабық; 3 - қуыстар; 4 - қабықасты қабықша; 5 - ауалы камера; 6 - сұйық ақзат; 7 - тығыз ақзат; 8 - ұрық дискісі; 9 - ақзаттық қабықша; 10 - бұршақ; 11 - сарыуыз қабықшасы; 12 - қара сарыуыз; 13 - ақшыл сарыуыз.

Жұмыртқаны органолептикалық зерттеу

- Іс жүргізу
- Автоматтандыру, Техника
- Алғашқы әскери дайындық
- Астрономия
- Ауыл шаруашылығы
- Банк ісі
- Бизнесті бағалау
- Биология
- Бухгалтерлік іс
- Валеология
- Ветеринария
- География
- Геология, Геофизика, Геодезия
- Дін
- Ет, сүт, шарап өнімдері
- Жалпы тарих
- Жер кадастрі, Жылжымайтын мүлік
- Журналистика
- Информатика
- Кеден ісі
- Маркетинг
- Математика, Геометрия
- Медицина
- Мемлекеттік басқару
- Менеджмент
- Мұнай, Газ
- Мұрағат ісі
- Мәдениеттану
- ОБЖ (Основы безопасности жизнедеятельности)
- Педагогика
- Полиграфия
- Психология
- Салық
- Саясаттану
- Сақтандыру
- Сертификаттау, стандарттау
- Социология, Демография
- Спорт
- Статистика
- Тілтану, Филология
- Тарихи тұлғалар
- Тау-кен ісі
- Транспорт
- Туризм
- Физика
- Философия
- Халықаралық қатынастар
- Химия
- Экология, Қоршаған ортаны қорғау
- Экономика
- Экономикалық география
- Электротехника
- Қазақстан тарихы
- Қаржы
- Құрылыс
- Құқық, Криминалистика
- Әдебиет
- Өнер, музыка
- Өнеркәсіп, Өндіріс
Қазақ тілінде жазылған рефераттар, курстық жұмыстар, дипломдық жұмыстар бойынша біздің қор #1 болып табылады.



Ақпарат
Қосымша
Email: info@stud.kz